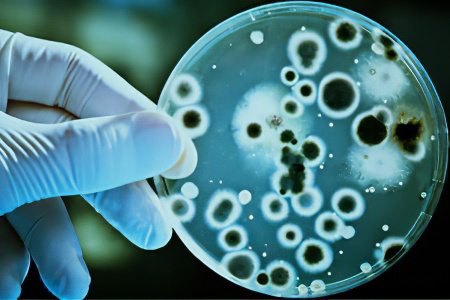

Возбудитель болезни – простейшая амеба
Амебиаз вызывается простейшим микроорганизмом — амебой, которая проходит два этапа жизненного цикла: вегетативный и стадию цисты, когда амеба находится в состоянии покоя.
В вегетативной стадии амеба может принимать различные формы:
- Тканевая форма. Эти амебы отличаются высокой подвижностью и способны проникать в разные среды, вызывая острое воспаление внутренних органов хозяина.
- Большая вегетативная форма. Эти амебы могут поглощать эритроциты.
- Просветная форма. В этой стадии амебы теряют подвижность и существуют в кишечнике во время выздоровления человека.
На стадии цисты амеба может принимать две формы:
- Предцистная форма. В этой стадии амеба менее подвижна и может существовать вне организма человека, сохраняя активность в течение нескольких месяцев при благоприятных условиях.
- Циста. Эта форма амебы способна выживать вне организма человека на протяжении нескольких месяцев. В почве она может оставаться активной до 7 дней. Амеба устойчива к холоду и сохраняет жизнеспособность при температуре -20 градусов, но погибает при высыхании.
В отличие от цист, вегетативные формы амебы не устойчивы к внешним условиям. При остром течении заболевания в испражнениях пациента можно обнаружить просветные и тканевые формы амеб. По мере выздоровления в кале начинают появляться цисты, а также просветные и предцистные формы.
Циста может долго сохранять жизнедеятельность вне человеческого организма. Она представляет собой сферическую четырехъядерную вакуоль, окруженную бесцветной оболочкой. После попадания цисты в тонкий кишечник из нее выходит зрелая амеба, которая начинает делиться. Каждая зрелая амеба образует 8 новых амеб с одним ядром, и все молодые амебы обладают способностью к размножению. В толстый кишечник они попадают в вегетативной форме.
Врачи отмечают, что амебиаз является серьезным инфекционным заболеванием, вызываемым простейшими микроорганизмами рода Entamoeba. По их мнению, основными путями передачи инфекции являются загрязненные вода и пища, что делает профилактику особенно важной. Специалисты подчеркивают, что симптомы могут варьироваться от бессимптомного носительства до тяжелых форм с диареей и абдоминальными болями. Врачи рекомендуют своевременно обращаться за медицинской помощью, так как запущенные случаи могут привести к серьезным осложнениям, включая перфорацию кишечника. Лечение обычно включает применение специфических антипротозойных препаратов, однако важно также учитывать состояние пациента и возможные сопутствующие заболевания. Профилактика, по мнению врачей, заключается в соблюдении правил гигиены и безопасного питания, особенно в регионах с высоким риском заражения.

Пути заражения
Распространителем амебиаза является инфицированный человек, который выделяет в окружающую среду различные виды амеб и их цисты. Заразность сохраняется даже после окончания острого периода болезни, и больной может выделять амебы на протяжении нескольких лет. В среднем, за сутки из организма больного выделяется около 9 миллиардов амеб. В острую фазу заболевания человек не является источником инфекции, так как в этот период он выделяет только вегетативные формы амеб.
Заражение происходит при попадании цист в организм, что может произойти через употребление немытых продуктов или из-за недостаточной гигиены (например, грязные руки). Опасность представляют также немытая посуда, личные вещи и постельное бельё. Переносчиками инфекции могут быть насекомые, такие как мухи и тараканы.
Наиболее подвержены амебиазу мужчины в возрасте от 20 до 50 лет. После перенесённой инфекции иммунитет не формируется. Заболевание широко распространено в странах с влажным и жарким климатом, хотя случаи инфекции фиксируются по всему миру.
Когда циста попадает в кишечник, она превращается в вегетативную форму и проникает в стенку кишечника. Здесь начинается выработка веществ, разрушающих ткани органа, что приводит к образованию язв. Язвы формируются из участков эрозий и абсцессов, которые выглядят как узелки. При разрушении узелка вегетативные формы амеб выходят наружу, а на его месте образуется язва, которая может достигать 25 мм в диаметре.
Язвы могут сливаться, и чем больше их количество, тем выше риск поражения мышечного слоя кишечника, что может привести к его перфорации. Это состояние представляет серьёзную угрозу для жизни, так как может вызвать перитонит.
Повреждение стенок сосудов может привести к кровотечениям различной степени тяжести. Когда стенки кишечника начинают заживать, это может вызвать сужение его просвета и непроходимость.
Если амебы проникают в кровоток, они могут распространяться по организму, достигая печени, лёгких и головного мозга. В случае хронизации заболевания существует риск образования опухолевидной амебомы в просвете кишечника, состоящей из грануляционной ткани и клеток организма.
| Симптом | Тяжесть | Возможные осложнения |
|---|---|---|
| Асимптоматическое носительство | Легкая | — |
| Диарея (водянистая, слизистая, кровянистая) | Легкая-средняя | Дегидратация, малокровие |
| Спастические боли в животе | Легкая-средняя | — |
| Тошнота, рвота | Легкая-средняя | Дегидратация |
| Вздутие живота | Легкая-средняя | — |
| Потеря веса | Средняя-тяжелая | Кахексия |
| Лихорадка | Средняя-тяжелая | Сепсис |
| Гепатит | Средняя-тяжелая | Печеночная недостаточность |
Формы амебиаза
Существует три основных типа амебиаза:
- Кишечный тип.
- Внекишечный тип (печеночный и другие).
- Кожный тип.
Амебиаз — это заболевание, о котором многие слышали, но не все понимают его серьезность. Люди часто делятся своими историями о том, как они или их близкие столкнулись с этой инфекцией. Некоторые рассказывают о том, как долго не могли понять, что происходит с их здоровьем, пока не обратились к врачу. Симптомы, такие как диарея, боли в животе и общее недомогание, могут быть очень неприятными и пугающими.
Многие отмечают, что амебиаз чаще встречается в странах с низким уровнем санитарии, и это подчеркивает важность соблюдения гигиенических норм. В социальных сетях можно встретить советы по профилактике, такие как мытье рук и употребление только очищенной воды. Однако не все понимают, что лечение амебиаза требует медицинского вмешательства, и самолечение может привести к серьезным последствиям. В целом, обсуждение амебиаза поднимает вопросы о здоровье, гигиене и доступности медицинской помощи в разных регионах.

Кишечная форма болезни
Наиболее распространенной формой заболевания является кишечная амебиаз. Продромальный период, который начинается с момента попадания амеб в организм и заканчивается появлением первых симптомов, может длиться от 7 дней до 3 месяцев.
Степень выраженности симптомов зависит от тяжести заболевания и нарастает постепенно.
У пациентов могут наблюдаться следующие признаки инфицирования:
- Повышение температуры тела до субфебрильных значений.
- Увеличение чувства слабости.
- Головные боли.
- Повышенная утомляемость.
- Боли в животе, которые не являются слишком интенсивными. Чаще всего пациенты отмечают ощущение распирания в кишечнике.
Основным признаком кишечной формы заболевания является диарея. Она может быть обильной, с частотой до 10-30 раз в сутки. В кале присутствует слизь, а по мере прогрессирования болезни диарея усиливается. Каловые массы теряют свою форму и становятся жидкими, в них может появляться кровь, а стул напоминает малиновое желе.
Боли в животе становятся более интенсивными и имеют схваткообразный характер. Острые симптомы могут сохраняться до 7 дней, после чего наступает облегчение, и заболевание переходит в стадию ремиссии. Однако через несколько недель или даже месяцев может произойти обострение, что характерно для рецидивирующего кишечного амебиаза.
Иногда заболевание протекает непрерывно, с периодами угасания и повторного усиления симптомов. Без лечения амебиаз может беспокоить человека на протяжении многих лет (до 10 и более).
Хроническая форма инфекции приводит к астеническому синдрому, из организма теряются белки и витамины. Язык покрывается плотным налетом, аппетит снижается. Кожа становится сухой, а черты лица заостряются. При пальпации живота пациент испытывает боль.
Лечение кишечного амебиаза крайне необходимо. В отсутствие терапии могут развиться серьезные осложнения. Поражается сердце, у больного могут возникнуть брадикардия и аритмия, миокард недополучает необходимые питательные вещества.
Длительное течение амебиаза негативно сказывается на нервной системе. Человек может впадать в депрессию или апатию, у него наблюдаются частые изменения настроения и повышенная раздражительность.
При тяжелом течении заболевания могут возникнуть следующие осложнения:
- Разрыв стенки кишечника.
- Стриктуры кишечника.
- Кишечное кровотечение.
- Периколит. Это осложнение встречается примерно у 10% пациентов и проявляется симптомами, схожими с перитонитом. Кишечные стенки могут слипаться из-за фибринового налета, образуя спайки и язвы.
- Гнойный перитонит. Присоединение гнойного процесса сопровождается усилением болей, повышением температуры до лихорадочных значений, рвотой, вздутием живота и значительным ухудшением состояния.
- Опухолевое новообразование в кишечнике (амебома). Оно может развиваться в слепой кишке и восходящем отделе толстого кишечника, часто приводя к кишечной непроходимости.
- Полипы кишечника. При амебиазе в кишечнике могут образовываться аденоматозные новообразования.
- Выпадение прямой кишки.
- Амебный аппендицит. Это осложнение характеризуется тяжелым течением и в 90% случаев может привести к летальному исходу, развиваясь во время острого периода болезни.
Печёночная форма болезни
При попадании амеб в печень может развиться гепатит или абсцесс. У пациента возникают сильные боли в правом подреберье.
Амебные абсцессы печени могут осложняться гнойными формами перитонита, плевритами и перикардитами. Смертность среди таких больных превышает 25%.
Во время пальпации печени врач может заметить её увеличение, повышенную плотность и болезненность. Иногда у пациента наблюдается желтушность кожи и слизистых оболочек. Температура тела может достигать высоких значений.
Боли могут иррадиировать в плечевой сустав и усиливаться при глубоком вдохе. Изменение положения тела также может спровоцировать приступ.
Температура тела нестабильна и может колебаться в течение дня. Пациент выглядит истощенным, его кожа становится сухой и теряет упругость. Глаза западают, а скулы становятся более выраженными. В целом, состояние пациента выглядит болезненно.
Часто наблюдается отечность нижних конечностей, а живот увеличивается в объёме. При переходе заболевания в хроническую форму истощение усиливается. Абсцесс печени может быть как единичным, так и множественным. Печёночный амебиаз — серьёзное заболевание, часто заканчивающееся летальным исходом. Если гнойник прорывается, патологические массы попадают в брюшную полость, вызывая симптомы перитонита. Гнойные массы могут также проникать в плевру, что приводит к развитию пневмонии или абсцесса лёгких. Такое воспаление часто имеет затяжной характер.

Другие формы амебиаза
Амебы могут перемещаться по организму с кровотоком. В некоторых случаях они достигают головного мозга, вызывая симптомы, указывающие на его поражение. У пациента возникают сильные боли, судороги, ухудшается чувствительность, а также могут развиться паралич или парез конечностей.
Кроме того, амебы проникают в селезенку, почки и женские половые органы. В этих местах они размножаются, что приводит к образованию абсцессов. Симптомы зависят от ухудшения работы конкретной системы организма.
Кожная форма болезни
При заражении амебами на коже образуются эрозии и язвы. В первую очередь поражаются ягодицы и область промежности. Язвы могут иметь разную глубину и не вызывают сильной боли, но от них исходит резкий неприятный запах.
Диагностика амебиаза
Для диагностики амебиаза необходимо провести осмотр пациента, выслушать его жалобы и назначить ряд лабораторных исследований.
В клиническом анализе крови можно заметить значительное увеличение количества лейкоцитов и рост скорости оседания эритроцитов (СОЭ).
Кал пациента исследуется на наличие амеб. Если у больного имеются симптомы внекишечного амебиаза, потребуется анализ мокроты и гноя из абсцессов или язв.
Отсутствие просветных форм амеб и цист в кале не исключает диагноз «амебиаз». Для выявления простейших необходимо сдать кал в лабораторию в течение 15 минут после дефекации, и анализ следует повторять несколько раз. Если заболевание ослабевает, каловые массы исследуют сразу после приема слабительного. Если невозможно доставить материал в лабораторию сразу, его следует законсервировать. Исследование проводят с использованием раствора Люголя. Амеб также можно культивировать на питательных средах, но результаты такого анализа могут занять много времени.
Иммунологический анализ является дополнительным методом диагностики. Наиболее эффективной считается реакция флуоресцентных антител (РФА), за ней следует реакция связывания комплемента. Еще одним способом диагностики является заражение выделениями с амебами лабораторных животных.
Инструментальные методы диагностики могут включать:
- Ректороманоскопия. Врач оценивает состояние сигмовидной и прямой кишки, что позволяет визуализировать язвы, эрозии, кисты, полипы и другие патологические образования, возникающие при амебиазе.
- УЗИ органов, которые могут быть затронуты амебами.
- КТ головного мозга, легких и других внутренних органов. Это исследование назначается при подозрении на распространение амеб через кровоток.
- Ирригоскопия. Метод исследования толстого кишечника, при котором пациенту вводят контрастное вещество и делают несколько рентгеновских снимков.
- Радиоизотопные методы. Эти исследования помогают отличить амебиаз от бактериальных инфекций кишечника или других органов.
- Микрорезонансная томография. Этот метод рекомендуется пациентам в ослабленном состоянии.
Лечение амебиаза
Лечение амебиаза включает использование медикаментов из трех основных категорий:
- Прямые амебоциты: Ятрен, Хиниофон, дийодохин, тетрациклиновые антибиотики. Эти препараты эффективно уничтожают просветные формы амеб. Их назначают как пациентам с хронической формой заболевания, так и выздоровевшим для предотвращения рецидивов.
- Тканевые амебоциты: Эметин, Хингамин, Амбильгар, Дегидроэметин. Эти лекарства нацелены на уничтожение амеб, обитающих в тканях и слизистых оболочках. Они применяются для терапии острого амебиаза или в случаях, когда инфекция затрагивает области вне кишечника.
- Универсальные амебоциты: Флагил, трихопол, Тинидазол, Фурамид. Эти препараты действуют на клетки паразитов изнутри, нарушая их белковый обмен, останавливая размножение амеб и способствуя образованию радикалов, которые уничтожают эти простейшие организмы.
Пациентам с амебиазом также назначают средства для восстановления кишечной микрофлоры (пробиотики). В зависимости от осложнений могут быть рекомендованы препараты для защиты печени и сердца, а также средства для повышения иммунной защиты.
При наличии анемии назначаются препараты с высоким содержанием железа и кровезаменители, в редких случаях — гемотрансфузин. Важно также принимать комплексные витамины, включая витамины группы В и аскорбиновую кислоту.
В случае тяжелого амебиаза проводится инфузионная терапия, что подразумевает внутривенное введение реополиглюкина и глюкозо-солевых растворов.
Схемы лечения амебиаза
Лечение кишечной формы заболевания проводится по следующим схемам:
- Метронидазол принимается внутрь трижды в день в течение 8-10 дней. Дозировка составляет 30 мг на килограмм массы тела в сутки.
- Тинидазол. Для детей младше 12 лет назначается 50 мг на килограмм массы тела в сутки, но не более 2 г за один прием. Для пациентов старше 12 лет доза составляет 2 г в сутки в один прием. Курс лечения продолжается 3 дня.
- Орнидазол. Детям до 12 лет назначают по 40 мг на килограмм массы тела в сутки, но не более 2 г в два приема. Для пациентов старше 12 лет доза составляет 2 г в сутки, разделенная на два приема. Курс лечения составляет 3 дня.
- Секнидазол. Для детей младше 12 лет доза составляет 30 мг на килограмм массы тела в сутки в один прием. Для пациентов старше 12 лет назначается 2 г однократно в сутки. Курс лечения продолжается 3 дня.
Если у пациента выявлен амебный абсцесс, схема лечения следующая:
- Метронидазол – 30 мг на килограмм массы тела в сутки, разделенные на три приема. Курс лечения составляет 8-10 дней.
- Тинидазол. Для детей до 12 лет назначается 50 мг на килограмм массы тела однократно. Для пациентов старше 12 лет доза составляет 2 г однократно в сутки. Курс лечения длится от 5 до 10 дней.
- Орнидазол. Детям до 12 лет назначают по 40 мг на килограмм массы тела в сутки, но не более 2 г в два приема. Для пациентов старше 12 лет доза составляет 2 г в сутки, разделенная на два приема. Курс лечения составляет 5-10 дней.
- Секнидазол. Для детей до 12 лет доза составляет 30 мг на килограмм массы тела в сутки в один прием. Для пациентов старше 12 лет назначается 2 г однократно в сутки. Курс лечения продолжается 3 дня.
Альтернативная схема терапии амебного абсцесса включает использование Дегидроэметина дигидрохлорида. Больным вводят 1 мг на килограмм массы тела в сутки внутримышечно, но не более 60 мг. Курс лечения составляет 4-6 дней. После завершения терапии этим препаратом пациентам с поражением печени назначается Хлорохин в дозе 600 мг в сутки на протяжении 2 дней, затем дозу снижают до 300 мг в сутки и продолжают прием еще в течение 14-21 дня.
Для полного устранения оставшихся в кишечнике простейших после основного курса лечения пациентам рекомендуется прием просветных амебоцидов. Это может быть Этофамид (по 20 мг на килограмм массы тела в сутки в два приема в течение недели) или Паромомицин (по 1000 мг в сутки в два приема в течение 5-10 дней).
Прогноз заболевания
Раннее обнаружение заболевания и начало лечения значительно повышают шансы на благоприятный исход. Без терапии амебиаз прогрессирует, что может привести к серьезным осложнениям и даже к летальному исходу.
Профилактика
Для предотвращения заражения следуйте следующим рекомендациям:
- Раннее выявление инфицированных и назначение соответствующего лечения.
- Регистрация всех перенесших заболевание на диспансерный учёт.
- Соблюдение санитарно-гигиенических норм: тщательно обрабатывать продукты перед употреблением, пить только чистую воду, регулярно мыть руки и выполнять другие гигиенические процедуры.
Вопрос-ответ
Что такое амебиаз простыми словами?
Амебиаз (амёбный колит, амёбная дизентерия) — это протозойное заболевание, которое вызывают амебы Entamoeba histolytica, являющиеся для человека патогенами. По различным данным амебиаз занимает третье место в мире среди паразитарных болезней по числу летальных исходов. Первые два места — у малярии и шистосомозов.
Чем опасен амебиаз?
При отсутствии своевременного лечения возможно развитие тяжелых осложнений амебиаза: перфорации кишечника, амебного аппендицита, кишечного кровотечения, прорыва абсцедирующих очагов.
Как передается амебиаз от человека к человеку?
Как можно заразиться амебиазом? Инфицирование происходит по фекально-оральному механизму. Источником инфекции является больной человек, который выделяет паразита с калом. Возбудитель может попасть в ЖКТ через грязные руки, при употреблении некипяченой воды из неизвестных источников.
Советы
СОВЕТ №1
Избегайте употребления некипяченой воды и непроверенных продуктов, особенно в регионах с высоким риском амебиаза. Пейте только бутилированную или кипяченую воду, а также тщательно мойте фрукты и овощи перед употреблением.
СОВЕТ №2
Регулярно мойте руки с мылом, особенно после посещения туалета и перед едой. Это поможет предотвратить распространение инфекций, включая амебиаз, и защитит вас и ваших близких.
СОВЕТ №3
Если вы планируете поездку в страны с высоким риском амебиаза, проконсультируйтесь с врачом о возможных вакцинациях и профилактических мерах. Это поможет снизить вероятность заражения.
СОВЕТ №4
При появлении симптомов, таких как диарея, боли в животе или лихорадка, немедленно обратитесь к врачу. Раннее обращение за медицинской помощью может значительно улучшить прогноз и ускорить выздоровление.